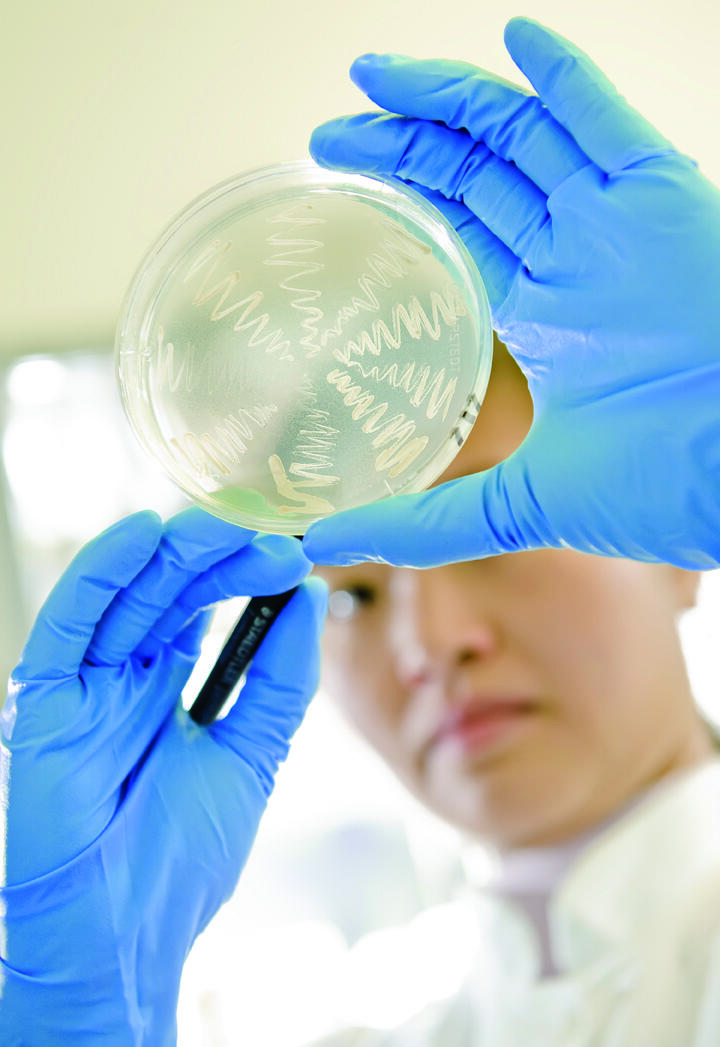
Hefe

Biotechnologische Produktion von Cortisol und markierten Referenzsubstanzen
Herstellungsverfahren verzichtet auf Markierung mit radioaktiven Isotopen
An markierten Referenzsubstanzen besteht ein erhebliches Interesse insbesondere seitens der forschenden Pharmaunternehmen, da diese Verbindungen große Bedeutung bei der quantitativen Analytik besitzen. Eines der Hauptprobleme bei der Verwendung dieser Methoden für pharmacokinetische Analysen besteht darin, dass häufig eine genaue Quantifizierung der zu untersuchenden Substrate innerhalb eines komplexen Probengemisches nicht direkt vorgenommen werden kann. Der Einsatz von Referenzsubstanzen zur genauen Quantifizierung hat sich als besonders effektiv herausgestellt. Jedoch sind diese Referenzsubstrate oftmals nicht kommerziell erhältlich, so dass andere Techniken oder sehr teure und umweltproblematische radioaktiv markierte Referenzsubstrate verwendet werden müssen.
Umweltaspekte
Die Biotechnologie ist nicht nur von großem industriellem Nutzen, sondern spielt auch in Umweltaspekten eine bedeutende Rolle. Im Gegensatz zu chemischen Verfahren erlauben biotechnologische Ansätze den Einsatz spezialisierter Enzyme, die spezifische Reaktionen unter umweltverträglichen Bedingungen katalysieren. Die Vorteile des entwickelten Verfahrens:
- Vermeidung umweltschädlicher Abgase
- Vermeidung der Produktion unerwünschter toxischer Nebenprodukte
- verringerter Einsatz von organischen Lösemitteln
- kostengünstige Produktion eines chemisch reinen Metaboliten
Ergebnisse
In dem vorliegenden Projekt wurden gentechnisch veränderte Hefen der Spezies Schizosaccharomyces pombe, die unter Verwendung ihrer natürlichen Kohlenstoffquelle in einem Fermenter kultiviert werden, für die Produktion von Cortisol und 4‘-Hydroxydiclofenac, einem Cytochrom-P450-Metabolit des Schmerzmittels Diclofenac, verwendet. Das Produkt dieser Ganzzellbiotransformation wird von den Hefen direkt in das Medium abgegeben, aus dem es einfach isoliert und anschließend gereinigt werden kann.
Projektthema
Umweltschonende und effiziente Produktion von Cortisol sowie nicht radioaktiver, Isotopen markierter P450-Metaboliten-Referenzstandards mittels Biotransformation
Projektdurchführung
Universität des Saarlandes
Lehrstuhl für Biochemie
Telefon 0681-302-3005
ritabern@mx.uni-saarland.de
www.uni-saarland.de
Projektpartner
PomBioTech GmbH
Telefon 0681-302-64901
matthias.bureik@pombiotech.de
www.pombiotech.de
ORGANOBALANCE GmbH
Telefon 030-46307200
lang@organobalance.de
www.organobalance.de
AZ 13220